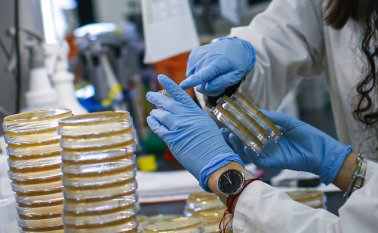
AFP

Artículo
El mundo vivirá en riesgo de nuevas pandemias
Se requieren sistemas de vigilancia epidemiológica eficaces, con una capacidad de diagnóstico rápido y certero.
Vida y salud
Vida y saludArtículo
‘Mi salud me mueve’, plataforma dirigida a concienciar sobre las enfermedades
La iniciativa digital de Pfizer es un movimiento en pro del bienestar de los colombianos.
Vida y salud
Vida y saludArtículo
Una de cada cuatro personas muere por culpa de la trombosis
En el Día Mundial de la Trombosis es importante destacar las graves consecuencias de la tromboembolia venosa y de la fibrilación auricular.
Publicidad
Artículo
Vida y salud
Vida y saludAntes del COVID-19, 7 enfermedades mortales de cada 10 eran no transmisibles
Seguir leyendo
Publicidad
Publicidad
Más noticias
Publicidad